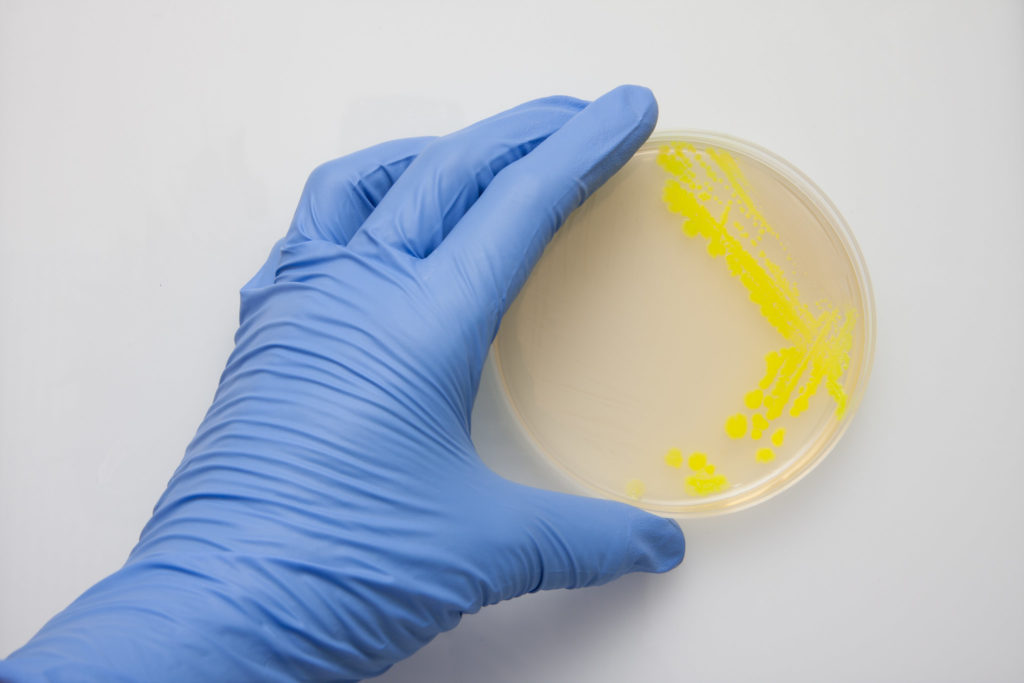

Vedci zaznamenali hrozivý trend, ktorý zabije ročne viac ľudí ako HIV/AIDS či malária. Navrhujú okamžité zavedenie opatrení
- Najnovší výskum ukazuje, že rezistentné baktérie zabili v roku 2019 až 1,2 milióna ľudí
- Zohrali roľu tiež v úmrtí 4,95 miliónoch ľudí na celom svete. Rezistentné baktérie tak zabili viac ľudí ako HIV/AIDS či malária
- Za mnohé úmrtia môžu bežné, predtým liečiteľné infekcie, ako sú infekcie dolných dýchacích ciest a krvného obehu
- Vedci zistili, že vysoké riziko je u ľudí všetkých vekových skupín, ale obzvlášť zraniteľné sú malé deti

Vedci neustále varujú, že antimikrobiálna rezistencia (AMR) u baktérií môže v budúcnosti spôsobiť veľké problémy. Už teraz čoraz viac štúdií ukazuje, že baktérie sú čoraz viac odolnejšie voči známym druhom liečiv. Najnovší výskum ukazuje, že rezistentné baktérie, známe ako superbaktérie, zabili v roku 2019 až 1,2 milióna ľudí, a zohrali roľu v úmrtí 4,95 miliónoch ľudí na celom svete. Čo je viac ako úmrtí na HIV/AIDS či maláriu.
Odhaduje sa, že HIV/AIDS a malária v roku 2019 spôsobili 860 000 a 640 000 úmrtí, tvrdia vedci vo vyhlásení.
„Dokonca aj dolná hranica 911 000 úmrtí odhadovaných štúdiou je vyššia ako počet úmrtí na HIV, ktorý každoročne stojí takmer 50 miliárd dolárov. Avšak globálne výdavky na riešenie AMR sú pravdepodobne oveľa nižšie, je to potrebné zmeniť,“ uviedol Dr Ramanan Laxminarayan z Centra pre dynamiku chorôb, ktorý sa výskumu nezúčastnil.
„Výdavky je potrebné nasmerovať v prvom rade na prevenciu infekcií, zabezpečiť, aby sa existujúce antibiotiká používali vhodne a uvážlivo, a uviesť na trh nové antibiotiká. Zdravotnícki a politickí lídri na miestnej, národnej a medzinárodnej úrovni musia prijať vážne, že je dôležité riešiť AMR a problém slabého prístupu k cenovo dostupným a účinným antibiotikám,“ dodal Laxminarayan.
Musíme konať hneď, varujú vedci
Štúdia, ktorá bola zverejnená v odbornom časopise The Lancet zistila, že za mnohé úmrtia môžu bežné, predtým liečiteľné infekcie, ako sú infekcie dolných dýchacích ciest a krvného obehu, pretože baktérie, ktoré ich spôsobujú, sa stali odolnými voči liečbe.
Vedci preto navrhujú okamžité zavedenie opatrení na monitorovanie a kontrolu infekcií. Navrhujú tiež investovanie do nových antibiotík i liečebných procedúr.
„Tieto nové údaje odhaľujú skutočný rozsah antimikrobiálnej rezistencie na celom svete a sú jasným signálom, že musíme konať hneď, bojovať proti hrozbe. Predchádzajúce odhady predpovedali 10 miliónov ročných úmrtí na antimikrobiálnu rezistenciu do roku 2050, ale teraz s istotou vieme, že už sme k tomuto číslu oveľa bližšie, ako sme si mysleli,“ uviedol spoluautor štúdie Chris Murray z Inštitútu pre metriky a hodnotenie zdravia na Washingtonskej univerzite v USA.

„Potrebujeme využiť tieto údaje na správnu činnosť a podporu inovácií, ak si chceme udržať náskok v pretekoch proti antimikrobiálnej rezistencii,“ dodal.
Nová štúdia skúmala rezistenciu baktérii v globálnom rozsahu. Zistili, že úmrtia po celom svete v roku 2019 sú spojené s 23 patogénmi a 88 kombináciami patogénov a liečiv v 204 krajinách a územiach.
Na vytvorenie odhadov rezistencie využili štatistické modelovanie. Pomohlo im pritom 471 miliónov individuálnych záznamov získaných zo systematických prehľadov literatúry, nemocničných záznamov a systémov, systémov dohľadu a iných zdrojov údajov.
Vedci sa pritom zamerali na dva spôsoby ako rezistenciu na antibiotiká dokumentovali, a to úmrtia spôsobené priamo AMR (teda úmrtia, ktoré by sa nevyskytli, ak by sa infekcie dali liečiť antibiotikami), a úmrtia spojené s AMR (úmrtia, kde sa vyskytla infekcia spôsobená rezistenciou, ale tento fakt mohol alebo nemusel byť priamou príčinou smrti).
Najsmrteľnejšia bola rezistencia spojená s infekciami dolných dýchacích ciest
Najčastejšie sa odolnosť voči liečivám prejavovala pri infekciách dolných dýchacích ciest, ako je pneumónia. Vedci zaznamenali až 400 000 úmrtí, ktorých príčinou bola infekcia dolných dýchacích ciest spojená s rezistenciou, a ďalších viac ako 1,5 miliónom úmrtí, pri ktorých rezistencia mohla zohrať rolu.
Odolnosť voči liekom pri infekciách krvi, ktorá môže viesť k život ohrozujúcej sepse spôsobila približne 370 000 úmrtí a bola spojená s takmer 1,5 miliónmi úmrtí. Lieková rezistencia pri intraabdominálnych infekciách, bežne spôsobených apendicitídou, viedla priamo k približne 210 000 úmrtiam a bola spojená s približne 800 000 úmrtiami.

Vedci zistili, že vysoké riziko je u ľudí všetkých vekových skupín, ale obzvlášť zraniteľné sú malé deti. Približne jedno z piatich úmrtí, ktoré možno pripísať AMR, sa vyskytuje u detí mladších ako päť rokov.
Krajiny trápi E. coli a Zlatý stafylokok
Napriek tomu, že v minulosti sa predpokladalo, že rezistencia na liečivá je problémom bohatých krajín, kde obyvatelia konzumujú antibiotiká ako lentilky, štúdia ukázala, že rovnako postihnuté sú i chudobné krajiny. Najviac prípadov sa vyskytlo v subsaharskej Afrike a južnej Ázii.
Z 23 študovaných patogénov sa ukázalo najnebezpečnejších šiestich z nich, a to Escherichia coli, Staphylococcus aureus (Zlatý stafylokok), Klebsiella pneumoniae, Streptococcus pneumoniae, Acinetobacter baumannii, Pseudomonas aeruginosa). Tieto patogény viedli priamo k 929 000 úmrtiam a boli spojené s 3,57 miliónmi.
Vyčíňanie patogénov sa líšilo podľa príjmu krajín. Vysoko príjmové krajiny potrápili Escherichia coli a stafylokok. Nízkopríjmové krajiny, naopak, baktérie spôsobujúce pneumónie.
Vedci upozorňujú, že ich štúdia má isté obmedzenia. Z mnohých častí sveta im chýbajú údaje, alebo ich neboli schopní analyzovať, pre náročnosť metodiky.
Čítaj viac z kategórie: Zaujímavosti
Zdroj: The Lancet









